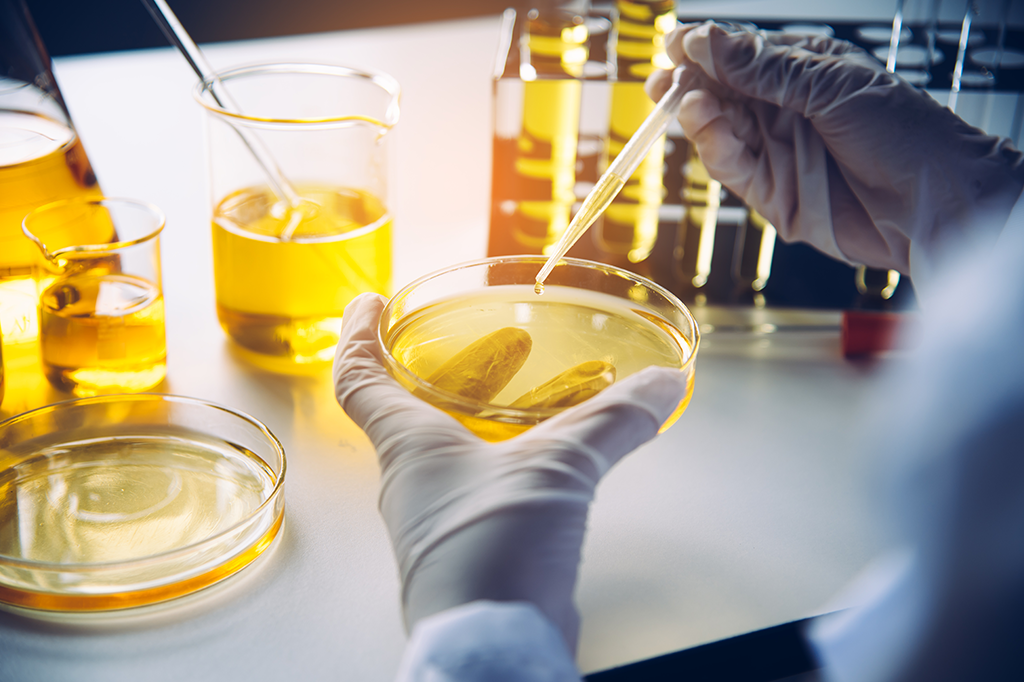
Used Oil Analysis

Used Oil Analysis
Access to oil analysis system

ILS Online Databases
Access to ILS CPM and Fleet Database

Orders
You are not setup for online ordering – Please contact customer services
Access to oil analysis system

Access to ILS CPM and Fleet Database

You are not setup for online ordering – Please contact customer services